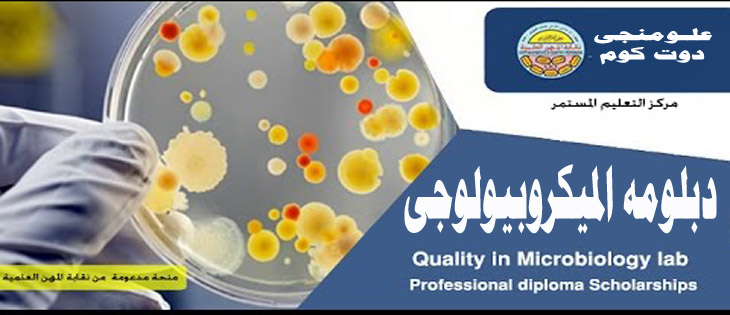

أوصى المجلس بالموافقة بشأن الخطاب الوارد من السيد الأستاذ الدكتور/ وكيل الكلية للدراسات العليا والبحوث والخاص بتوصية مجلس قسم النبات والميكروبيولوجي بجلسته المنعقدة بتاريخ4/9/2019م وتوصية لجنة الدراسات العليا والبحوث بجلستها المنعقدة بتاريخ 12/9/2019م بالموافقة علي قبول طلاب كلية الزراعة في دبلومة الميكروبيولوجي التطبيقية خلال العام الدراسي 2019/2020م من خريجي الشعب التالية:-
1- شعبة ميكروبيولوجي.
2- شعبة وراثة.
3- شعبة صناعات غذائية.
4- شعبة وقاية وامراض نبات.
قبول طلاب كلية الزراعة في دبلومة الميكروبيولوجي